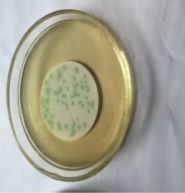

包装饮用水中铜绿假单胞菌检验疑难析释
发布时间:2019-09-04 浏览次数:15850 分享:
铜绿假单胞菌(Pseudomonas aeruginosa)是一种重要的水源性条件致病菌,广泛存在于各类型水中,对消毒剂、干燥、紫外线灯理化因素具有较强的抵抗力,可引起急性肠道炎、脑膜炎、败血症和皮肤炎症等疾病。近年来,铜绿假单胞菌污染桶装水的情况报道较多,是市面上包装饮用水最容易出现的质量问题;2018年山东、江苏、贵州、广东等多省市瓶(桶)装饮用水不合格率高发,主因是铜绿假单胞菌超标严重,该项目政府抽检不合格率远超其他抽检项目,质量安全问题十分严重,主要原因是生产企业没有做好日常生产过程的微生物监控,生产过程的消毒效果缺乏准确的验证方法,使得生产的产品质量失控。
GB8538-2016食品安全国家标准 饮用天然矿泉水检验方法是国家最新公布的针对包装饮用水铜绿假单胞菌的检验方法,检验程序如下:
标准的检测过程写的比较精炼,对于一般生产企业的检测人员来说在实际的检测过程中,会遇到比较多的问题,以下来对其中的可能的检测难点一一说明并推荐相应的解决办法。
操作步骤
1 水样过滤
取好的水样需在100级的洁净工作台用0.45um的滤膜进行抽滤,将微生物截留在滤膜上,再将滤膜贴在CN琼脂培养基上进行培养,应避免在滤膜和培养基之间夹留气泡。
这个步骤中有两个方面检测方法中未说明,一是采用何种滤器和如何灭菌,二是滤膜如何灭菌。
包装水生产企业可以购买专用的多联不锈钢过滤系统,一般材质是不锈钢的,可以用牛皮纸包好后直接放入灭菌锅内进行灭菌;也可以购买常见的砂芯过滤器,同样可以用牛皮纸包好后放入灭菌锅灭菌;如果需要使用的滤器数量较多,可以采用高温火焰喷枪灼烧方式灭菌,也可起到灭菌效果。滤膜可采用一次性无菌滤膜。

环凯多联不锈钢过滤系统

无菌微孔滤膜
2 滤膜在CN琼脂培养和观察
CN琼脂培养后的菌落形态分以下三种,其它情况为非铜绿假单胞菌:
(1)蓝色或绿色的典型可疑菌落,直接做绿脓菌素的确证性实验,这个现象比较明显,也容易辨认;
CN培养基上绿色菌落

绿脓菌素确证
(2)非蓝绿色而在365nm紫外灯照射下产荧光的菌落,这种类型的可疑菌落需进行乙酰胺肉汤确证性实验;

CN培养基上非蓝绿色而在365nm紫外灯照射下产荧光的菌落

乙酰胺确证试验
(3)是红褐色菌落紫外灯照射下也不产荧光,需进行氧化酶测试、乙酰胺液体培养基确证,金氏B培养基确证。
所有三种情况均需接种到营养琼脂培养基上进行纯化。
根据日常检测数据的统计,前两种的情况较多,第三种情况最少,而第二种即非蓝/绿色的产荧光的菌落最具有迷惑性,也是检验的难点所在,需要特别仔细的进行验证。
典型菌落的形态周围呈现融化的状态,菌落数较少的情况下,划线纯化比较简单;菌落数较多的情况划线就比较麻烦了,因为第一种典型可疑菌落是直接目测能看到的,而第二种情况产荧光是需要在360nm的紫外灯照射下才能看见是否产荧光,这就会可能导致划线纯化的时候可疑和典型菌落出现混淆错划的情况,会导致结果的截然不同。例如:挑取蓝绿色可疑菌落纯化时,因菌落溶解状扩大,可能挑取时不仅挑取到了蓝绿色可疑菌落,还挑取到其他类型可疑菌落,纯化后确证就可能导致结果完全改变的情况,解决办法是在这种菌落较多的情况下,可以采取计数后分开再在CN琼脂平板上划线一次,先在CN琼脂平板上分离中上述几种菌落的单个菌落,再划线接种到营养琼脂平板上纯化后进行确证试验,已避免因挑取典型菌落出现差错导致结果的偏差。
3 确证性试验
这里需特别注意的是上述的第二种情况,即非蓝/绿色产荧光的可疑菌落的产氨实验:
纯培养物接种到乙酰胺液体培养基36℃培养20~24h后,滴加1~2滴钠氏试剂,检查产氨实验,有出现从深黄色到砖红色的颜色变化,则为阳性,否则为阴性。
在实际过程中会发现确证试验出现这种颜色变化过程的比例很高,是很多都是阳性结果
经过使用生化试剂条鉴定发现有近六成的比例并不是铜绿假单胞菌,是什么原因呢,主要是时间的问题,时间比较久时,砖红色出现的几率比较高,会影响检测人员的判断,建议在3~5分钟内进行观察,并且一定要与阳性和阴性对照菌株进行比较观察,可有效降低误判。另外推荐一种简单的方法:如觉得还有疑问不能判定,可以从纯培养物接种划线到固体乙酰胺培养基进行培养,铜绿假单胞菌在固体培养基上的特征是灰白色,扁平,边缘不整齐,菌落周围培养基略带粉红色,可以结合固体和液体培养基的生长特征和现象进行判定,误判基本可以消除,此方法成本很低,一般的生产企业可以使用。
铜绿假单胞菌的污染主要来自三个方面,一是水源的污染,二是加工过程的污染,三是包装材料的污染,作为生产企业,需要通过提高自身的检测能力,分别监测这三个方面的污染情况,采取有效的消毒灭菌方式,并验证灭菌效果,可确保生产的产品质量安全有保障。
GB8538-2016铜绿假单胞菌检验操作过程中要考虑多种因素,实验周期长,对实验人员专业水平要求高。下面给大家介绍一种操作简便、检出率高的快检方法——铜绿假单胞菌恒温荧光核酸快速检测试剂盒。
1 铜绿假单胞菌恒温荧光核酸快速检测方法

与传统检测方法相比,省去繁琐的可疑菌落逐步确证的工作,一步判读结果,缩短结果报告时间,且实验操作对检验人员工作经验要求不高!
2 环凯铜绿假单胞菌核酸检测试剂盒组成

3 铜绿假单胞菌快速检测所需试剂、仪器及耗材列表

